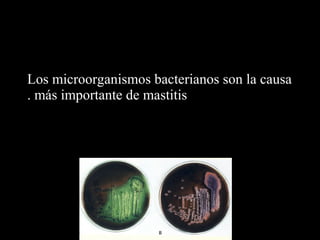
Los microorganismos bacterianos son la causa
. más importante de mastitis

Este documento trata sobre el control de la mastitis en el rodeo lechero. Resume los principales puntos como el pago por calidad de leche según recuento bacteriano y células somáticas, la importancia de un buen manejo del ordeño y la máquina de ordeño, el tratamiento de casos clínicos y de secado, y establecer objetivos realistas de sanidad de ubre. Además, explica conceptos como acidez de la leche y su relación con el pago.

![Acidez
• La acidez de una solución depende de la concentración de
iones Hidrogeno [H +] que hay en ella.
• Cuando la concentración de iones [H+] e iones [OH+]
hidroxilos es igual la solución es neutral.
• En una solución neutral el numero de [H+] por litro es de
1:10 000 000 g o 0,000 0001 g/l o 10-7](https://image.slidesharecdn.com/fepalemodulo32013-131025142135-phpapp02/85/Mastitis-Modulo-3-12-320.jpg)
![Acidez
El pH representa la concentración de iones Hidrogeno de
una solución y puede ser definida matemáticamente
como el logaritmo negativo de la concentración [H+].
Entonces el pH de una solución neutral es
pH = - log 10 -7 = 7](https://image.slidesharecdn.com/fepalemodulo32013-131025142135-phpapp02/85/Mastitis-Modulo-3-13-320.jpg)
![Acidez
• Cuando la concentración de [H+] es de 1:1 000 000 g/litro
la concentración es de 10 -6 siendo el pH de 6, y la
solución es acida.
• La leche normal es ligeramente acida entre 6.5 a 6.7,
normalmente 6.6 cuando se mide con un pHmetro a
temperatura de 25 oC.](https://image.slidesharecdn.com/fepalemodulo32013-131025142135-phpapp02/85/Mastitis-Modulo-3-14-320.jpg)
![Acidez titulable
• La acidez puede ser expresada también como acidez
titulable. Esta es la cantidad de iones hidroxilo [OH-]
necesarios para alcanzar un pH de 8.4 utilizándose un
indicador como la fenolftaleina, la cual cambia de incoloro
a rosa.
• Es decir cuanto alcalinidad necesito para cambiar el color
desde un pH 6.6 a 8.4.
• A medida que haya mas actividad bacteriana mayor será la
cantidad de álcali que se utilizara para obtener el cambio
de color](https://image.slidesharecdn.com/fepalemodulo32013-131025142135-phpapp02/85/Mastitis-Modulo-3-15-320.jpg)























































